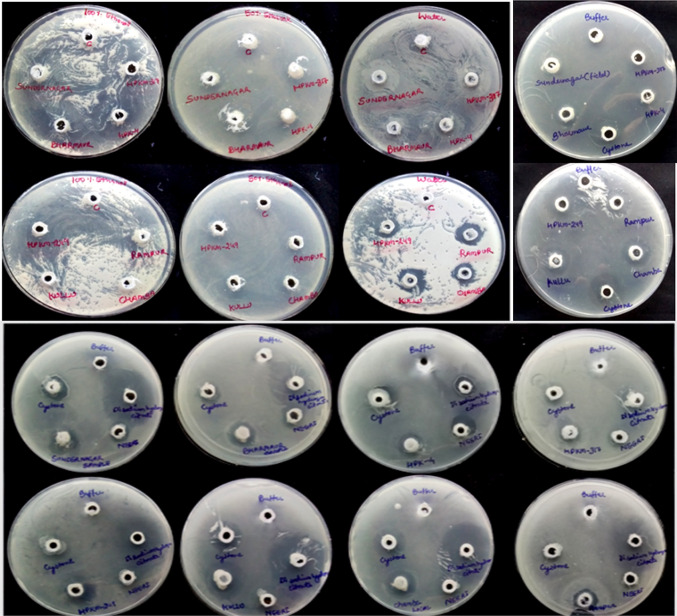
Fig. 2

Abstract
Seeds of Macrotyloma uniflorum collected from different Himalayan regions of Himachal Pradesh, India were screened for inhibition potential of calcium oxalate crystals along with their antioxidant and amino acid profiling. Aqueous, ethanol, 50% ethanol extracts were tested using agar-gel overlay, nucleation, and artificial urine methods in comparison to marketed products. The aqueous extract of Sundernagar and Rampur seeds showed highest inhibition potential (9.0 ± 0.81 mm) than alcohol and hydroalcohol. Sundernagar seeds (aqueous extract) also showed maximum inhibition (45 ± 1.2 and 24 ± 0.88%) in nucleation and artificial urine assay, respectively. The Tris-buffer (pH. 8.0) extract of dry seeds showed more inhibition with low protein than high protein germinated seeds. The findings revealed that horse gram protein is not alone responsible for CaOx-crystals inhibition but its secondary metabolites may also contribute. Among all samples, buffer and aqueous extracts showed maximum activity, followed by hydroalcohol and alcohol. Further, TLC and UPLC method were used to monitor the presence of amino acids in aqueous and Cystone extracts. Sundernagar seeds contain 11 amino acids with additional arginine, aspargine, and methionine. Moreover, higher antioxidant potential was observed in seeds of high altitude, which relates the factors of altitudinal variation in secondary metabolism of plants. Therefore, this study will help in the development of economical and more reliable plant based nutraceuticals for kidney stone problems and related health issues.
Electronic supplementary material
The online version of this article (10.1007/s13205-020-02394-z) contains supplementary material, which is available to authorized users.
Keywords: Macrotyloma uniflorum, Kidney stones, Urolithiasis, Calcium oxalate crystal inhibition
Introduction
Therapeutic potential of medicinal plants has been evaluated for many centuries because of their richness in remedial agents and minimum side effects. Earlier literature exposed the highest number of anti-urolithiatic plant species belonging to the family Fabaceae (Ahmed et al. 2017). The Fabaceae family is not only useful for antilithiatic potential, but other plant families such as Caryophyllaceae and Apiaceae have also contributed to the treatment of urinary stones (Doddola et al. 2018). Macrotyloma uniflorum, commonly known as horse gram, is well adapted to less fertile and stressful environments and is cultivated around the world, mainly in India, Burma, Sri Lanka Australia, and Africa. In India, it is grown mainly in Himachal Pradesh, Sikkim, Maharashtra, Andhra Pradesh, Karnataka, and Tamil Nadu (Kadam et al. 1985; Prasad and Singh 2015). In Himachal Pradesh, it is cultivated from low elevation to high elevation with different climatic conditions, majorly in Chamba, Kullu, Shimla, Sirmour, Mandi, Kangra districts (Gautam et al. 2020). It contains several nutritive and anti-nutritive substances like protein, fibers, carbohydrates, phytic acid, phenolic acid, enzymatic inhibitors, and other essential diet elements (Pal et al. 2016; Gautam et al. 2020). From the prehistoric period, it is well-practiced for the treatments of various ailments such as kidney stones, leucoderma, urinary troubles, and heart diseases (Ghani 1998; Yadava and Vyas 1994; Handa et al. 2017). However, scientific evidence is still needed to generate in most of these cases. Senthil (2009) reported the role of M. uniflorum extract in lowering lipidaemic and glycaemic indexes. Further, the extract of this pulse crop was used to treat several health-related problems like urine infections, pregnancy, menstruation, constipation, rheumatism, and intestinal worms (Pati and Bhattacharjee 2013). The high therapeutic potential and nutritional value increased the popularity of this indigenous pulse with a future perspective (Gautam et al. 2020). In India, around 12% of the total populations were predicted to have urolithiasis, whereas, nearly 15% of this was inhabited in the Northern part of India (Abbagani et al. 2010). Urolithiasis is the formation of urinary calculi (composition: Ca-oxalate, Ca-phosphate, and remaining 20% is struvite, cystine, uric acid, and other stones) in urinary tract system (Vidhya et al. 2013; Ahmed et al. 2017). Urinary calculi formation is a complex process and occurs due to the supersaturation, nucleation, growth, aggregation, and retention within the renal tubules (Yadav et al. 2011). The occurrence of urinary stones is the third most frequent disease that starts with obstruction of the urinary tract and results in severe infections and bleeding (Hadjzadeh et al. 2007). The available treatments are painful and expensive. Moreover, synthetic drugs like diuretics and narcotic analgesics are used in the prescriptions, but excess intake causes severe and prolonged adverse effects. Therefore, most of the populations rely on safer natural remedies that are readily available. The reoccurrence chances of diseases with natural drugs are very less due to their innate antioxidant potentials (Binu and Vijayakumari 2014; Santhoshi et al. 2015). Natural products have antioxidant potential due to their complex metabolite nature, which results in the scavenging of free radicals and protects from inflammation kidney stones (Khan 2014). Further, M. uniflorum is extensively explored for its nutritional and antilithiatic potential. However, the effects of different varieties on dietary potential, antioxidant, and antilithiatic activity need to be investigated for the identification of lead cultivars and their commercial implication.
Materials
Plant material
Macrotyloma uniflorum seeds were collected along with the information of latitude/longitude, altitude, temperature (min. to max.), precipitation from different locations of Himachal Pradesh a north-western states of India, such as Kullu [31.84° N/77.16° E, 1090, (16–29 °C), 118 mm], Chamba [32.72° N/76.05° E, 1829, (14–29 °C), 159 mm], Rampur [31.45° N/77.63° E, 1021, (20–28 °C), 127 mm], Sundernagar [31.38° N/77.20° E, 1404, (18–26 °C), 190 mm], Bharmour [32.26° N/76.32° E, 2195, (17.8–27.5 °C), 110 mm] and Palampur [32.10° N/76.30° E, 1290, (22–31 °C), 600 mm]. The seeds (HPK-4, HPKM-317, and HPKM-249) from the Palampur region were procured from the Department of Agricultural Biotechnology, CSK, Himachal Pradesh Krishi Vishwavidyalaya H.P., India. All the seeds were authenticated Macrotyloma uniflorum (HP-MU) by Dr. RK Chahota from the Department of Agriculture Biotechnology, CSK Himachal Pradesh Agricultural University, Palampur. The seeds were ground to a coarse powder and stored at room temperature.
Methods
Extraction of M. uniflorum seeds
Macrotyloma uniflorum seed materials (1:3) were extracted with water, ethanol, and 50% ethanol using an ultra-sonication method (Ying et al. 2011). The sample mixtures were centrifuged at 12,000 rpm for 20 min, and the supernatant was taken for further study. The seed materials of all locations were also extracted with buffer [1 gm seed powder was mixed in 3 mL of buffer (pH 8.0) consisting Tris base (0.05 M), polyethylene glycol (1.0%-H 4000), cysteine hydrochloride (0.1%), ascorbic acid (0.1%), citric acid (0.007 M) and β-mercaptoethanol (1 mM)]. All sample mixtures were homogenized for 10 min and centrifuged at 18,000 rpm for 20 min at 4 °C (Arulsekar and Parfitt 1986). The supernatant of each sample was used for the screening of calcium oxalate inhibition potential (Ranjan et al. 2012). Surface-sterilized seeds of all locations incubated for 72 h at room temperature for germination. Seeds of all the samples were crushed and extracted with Tris-buffer under cold conditions. The extracted samples were filtered and centrifuged at 12,000 rpm for 20 min at 4 °C, and supernatants were assayed for calcium oxalate inhibition potential along with their respective controls. The proteins in all the samples were also estimated by the Bradford method (Bradford 1976).
Calcium oxalate (CaOx) crystal inhibition potential
The CaOx crystals inhibition potential of different M. uniflorum extracts were investigated by agar-gel overlay assay, nucleation assay, and artificial urine method.
Agar gel overlay assay (Anita et al. 2017)
The autoclaved petri plates were over layered with 25 mL of 0.8% of bactoagar, containing 0.2 M CaCl2 and allowed to solidify. Then wells were prepared, and extracts of different seeds (100µL) were poured into the wells. The experimental plates were kept in the incubator at 37 °C for 16–18 h, for the diffusion of inhibitory bioagents from the crude extracts into over layered agar gel. The detection of crystal inhibition was noticed by immersing the experimental petri plates in a 0.2 M ammonium oxalate solution. This results in the formation of CaOx crystals by reacting with each other on the gel surface. The inhibition zones on gels marked the CaOx crystals inhibition by the respective extracts and were recorded in mm (Hostettmann 1999).
Nucleation assay
The classical turbidimetric method of CaOx crystals inhibition described earlier (Hennequin et al. 1993). The solutions of calcium chloride (3 mM) and sodium oxalate (3 mM) were prepared in a Tris-buffer with final pH 6.5 (0.5 mM Tris in 0.15 mM NaCl). For the assay, 950µL of calcium chloride and 100µL of sample extract was pipette out against a blank (without extract) and then added 950 µL of sodium oxalate. The mixture was well mixed, and absorbance was measured at 620 nm.
Artificial urine (AU)
Burns and Finlayson method was used for preparing AU with reagents’ sodium citrate (3.21 mM), sodium chloride (105.5 mM), magnesium sulfate (3.85 mM), sodium sulfate (16.95 mM), sodium phosphate (32.3 mM), potassium chloride (63.7 mM), calcium chloride (4.5 mM), ammonium hydroxide (17.9 mM), sodium oxalate (0.32 mM), and ammonium chloride (0.0028 mM). The final pH of the AU was adjusted to 6.0. For control, 1 mL of AU was used as a control, and 0.5 mL of distilled water was taken as blank. The 0.5 mL of 0.01 M sodium oxalate added to the AU and absorbance was measured for ten minutes. For a test, the mixture of 1 mL of AU with 0.5 mL of seed extracts was added to the test tubes, and blank reading was taken, then 0.5 mL of 0.01 M sodium oxalate solution was added to the same test tubes, and absorbance was measured for ten minutes at 620 nm (Rupam et al. 2017). The inhibitory percentage for CaOx crystals formation was calculated using the following formula:
where Test is the absorbance of extract, and control is the absorbance of blank (Srinivasa et al. 2013).
Optimization of concentration for maximum CaOx crystals inhibition potential
The concentration ranges from 3 to 30 mg of individual dry seed buffer extracts showed maximum inhibition potential, and further it was checked to find out the minimal inhibitory concentration in the agar-gel overlay method.
DPPH radical scavenging activity
The antioxidant activity of the extracts was measured by free radical scavenging activity of stable 1,1-diphenyl 2-picrylhyorazyl (DPPH) free radical, as mentioned by Kumaran and Karunakaran (2005). DPPH free radical scavenging has to peek absorbance at 517 nm. But, in the presence of antioxidants, the color of the reaction mixture decolorizes, and the absorbance was decreased. The 3 mL of a DPPH (0.004%) solution prepared in methanol was added to 100µL of extract and standard ascorbic acid solutions, which were further incubated for 30 min under dark conditions. The absorbance was recorded at 517 nm against the blank. The percentage inhibiting activity was calculated from [(A0-A1)/A0] × 100, where A0 is the absorbance of the control, and A1 is the absorbance of the extract/standard. The IC50 value was also calculated.
Amino acid screening using thin layer chromatography (TLC)
TLC was performed on precoated silica gel 60 F254 (Merck, USA) plates using n-butanol/pyridine/Disttled H2O (1:1:1) as the mobile phase. The plates were dried and sprayed with 0.1% Ninhydrin solution and sparingly heated at a temperature of 50 °C for 2–3 min. The plates were investigated under 254 nm, 365 nm and white light in a UV chamber, and visible spots were marked (Stahl 1969).
Amino acid profiling using ultra-performance liquid chromatography
The qualitative and quantitative estimation of amino acids in samples of different locations were performed according to Agrawal et al. (2019) with minor modifications.
Sample extraction and derivatization
A total of 100 mg was extracted from each sample with 50% ethanol and the final volume was made up to 5 mL after centrifuging the seed extracts at 4ºC for 10 min at 12,000 rpm. The mixtures containing 10 mL borate buffer, 50 mg O-phthaldialdehyde, and β-mercaptoethanol were dissolved uniformly and filtered using 0.45 µm membrane filters. The prepared solution was mixed with samples in equal ratio and again filtered through syringe filters (0.45 μm). The final filtrates were injected into UPLC for next-level analysis.
Amino acid analysis
The analysis of free amino acid was done by using the UPLC system (Waters Acquity-UPLC-H.) The solution of 0.14 mol/L sodium acetate (pH 6.7) containing triethylamine with glacial acetic acid and methanol (90:10) was taken as mobile phase A. While, 60% acetonitrile was used as mobile phase B. The presence of free amino acids was monitored in an injection volume of 1 μL at 254 nm and quantified with a calibration curve using a standard amino acid mixture (Sigma Aldrich, India).
Statistical analysis
Past 3.0 software was used to determine the correlations in terms of discrimination and similarities among the distinct samples with the utilization of CaOx crystal inhibition information. The data are mean ± SEM, centered, normalized, and subjected for statistical analysis such as heat map (matrix plot) and correlation (PCA, PCoA, HCA) and other statistical analysis.
Results and discussion
An important factor in renal stone formation is nucleation, which involves the growth of crystals and their aggregation. Natural resources with nucleation inhibition and oxalate supersaturation reduction are essential to treat urolithiasis (Patel and Acharya 2020). Soup of M. uniflorum seeds is traditionally used to dislocate the kidney stone in this North-Western Himalayan region (Singh et al. 2017). Therefore, the present study is focused on to investigate this capability of horse gram seeds of different landraces, collected from different locations of Himachal Pradesh (Fig. 1) and were screened for CaOx crystal inhibition potential using various methods.
Fig. 1.
Farmer’s varieties of M. uniflorum (Dry and germinated) in Himachal Pradesh, India
Calcium oxalate crystal inhibition
Ethanol, 50% ethanol, and distilled water extracts were screened for inhibition assay by agar-gel overlay method, including commercial products available in the market with respect to blanks. Clear zones of CaOx crystallization inhibition were observed, and diameters of zones were measured manually (mm). Among the above three extracts, the water extract of Sundernagar and Rampur seeds showed a reasonable zone of inhibition (9 ± 0.81 mm). There was no activity in ethanol extracts, while hydroalcoholic extracts (50% ethanol) resulted in very less in comparison to water extracts (Fig. 2; Table SI-1). The water extract was found more effective in agar-gel overlay method than NEERI and comparable with Cystone, while less effective than Disodium hydrogen citrate (DSHC). Moreover, buffer (Tris-buffer; pH. 8.0) extracts of dry and germinated seeds (After 72 h incubation) of different locations were also screened for the inhibition activity. The dry seeds buffer extract showed more inhibition [Rampur (10 ± 0.72 mm) > Bharmour (9 ± 0.65 mm) and Chamba (9 ± 0.69 mm) > Palampur (HPK-4, 8 ± 0.18 mm) > Sundernagar (7 ± 0.56 mm) > Kullu (6 ± 0.11 mm)] than the germinated seed. In nucleation assay and artificial urine, maximum inhibition was observed in aqueous extracts of Sundernagar i.e., 45 ± 1.2 and 24 ± 0.88%, respectively (Fig. 3; Table SI-2). Similarly, buffer extract of dried Bharmour sample showed the highest inhibition in nucleation assay and artificial urine (86 ± 2.01% and 89 ± 3.33%, respectively) in comparison to other samples and marketed products (DHSC: 82 ± 2.52%; Cystone: 54 ± 3.01% and NEERI: 50 ± 2.26%) in artificial urine while Disodium citrate: 16 ± 1.06%; Cystone: 6 ± 0.62% and NEERI: 4 ± 0.09% in nucleation assay). Ethanol and 50% ethanol extracts showed no inhibition in nucleation (NA) and artificial urine (AU) assays. Among all extracts, buffer extracts showed the highest activity followed by water, hydro alcohol, and alcohol, similar to the previous locations. The results guided that activity might be due to the presence of more polar as well as water-soluble compounds. Similar findings were also made by Netrapal et al. (2019). They reported that the aqueous extract and total protein were responsible for the reduction in the size of both CaOx crystals and human kidney stones. Therefore, the protein content was also estimated in all seed samples. The protein content was found higher in germinated seeds, followed by water and dry seed extracts (Table SI-3). Besides, the activity was found highest in dry seeds followed by water and germinated seed extracts of different locations. It was also earlier observed that the germination process decreases the phenolics content, which might be due to the increased activity of polyphenol oxidase and other catabolic enzymes (Singh et al. 2013). The current finding suggests that the protein was not only responsible for the activity, but polar compounds present in the seeds may also contribute to the activity (Fig. 3).
Fig. 2.
Effect of M. uniflorum samples and reference standards on CaOx crystallization inhibition
Fig. 3.
a Effect of M. uniflorum buffer extracts and reference standards on CaOx crystallization inhibition, b Protein content in farmer’s varieties of M. uniflorum and reference standards
Optimization of concentration for maximum CaOx crystal inhibition potential
Among all M. uniflorum seed extracts, the buffer and aqueous extract were found most suitable for the extraction of biocatalyst with high CaOx inhibition potential. The buffer extracts showed maximum inhibitory activity in nucleation and CaOx crystallization in artificial urine, while the results of the agar-gel overlay method were found comparable with others. Therefore, samples (Sundernagar, Bharmaur, HPK-4, Chamba, and Rampur region) having maximum zone inhibitions with remarkable CaOx inhibition potential were selected further. The concentration (3–30 mg/100µL) of five selected seed extracts was optimized for the maximum inhibition in the agar-gel overlay method. The diameter of control was subtracted from inhibition diameters of samples (10 mm) while the 3 mg/100µL concentration showed the same inhibition zone diameter (10 mm) for all five extracts (Fig. 4) concluding that more than 3 mg/100 µL sample quantity is required to show inhibition potential on agar plates. The maximum zone of inhibition (14 ± 0.86 mm) was marked with an amount of 27 mg/100µL concentrations of the Sundernagar sample. In contrast, the same amount of other locations showed a different pattern of inhibition (Bharmour: 10 ± 0.11 mm, HPK-4: 12 ± 0.99 mm, Chamba: 10 ± 0.77 mm and Rampur: 11 ± 1.01 mm, respectively).
Fig. 4.
Optimization of samples concentration for the zone of inhibition in agar-overlay method
Statistical analysis
The matrix plot was designed to get the information regarding discriminations and similarities among all samples for activities. HCA provides the neighboring joining of the activities in different samples as per their distances and inhibition of CaOx crystals. Perhaps, PCA-1 and PCoA-1 give similar information, whereas, PCoA provide clear differentiation idea among the seed samples from the marketed product. PCA was used for quantitative variables; the axis in graphic have a quantitative inhibition activity, different extractions methodology, and locations of the samples in relation to the activity. The PCA and PCoA showed around 85.057% variance in agar-gel overlay method (Fig. 5), while 67.409% similarity index (Euclidean) among all samples was observed in NA and AU method. Rampur, Bharmour, HPK-4 (Palampur), and Chamba showed good activity in comparison to Cystone and DSHC in the agar-gel overlay method, and a similar result was also seen in the NA and AU analysis led by Bharmour. The distances and discriminations in the PCA and PCoA plot marked (Fig. 5). Further, seeds of the above four locations can be used for the isolation and characterization of economical biocatalyst/bioagent responsible for the inhibition of CaOx crystallization and remedial products formulation.
Fig. 5.
Statistical analysis for CaOx crystallization inhibition by M. uniflorum varieties
Antioxidant activity
Free radicals play a crucial role in several health complications. High levels of imbalance between free radicals and antioxidants are one of the main reasons for cancer, diabetes, obesity, and aging (Halliwell and Gutteridge 1997). Therefore, free radical scavenging activity of selected M. uniflorum farmers’ varieties was also investigated using the DPPH assay. Whereas DPPH is a stable free radical, during a reaction, it gets reduced and visualized with a change in color from purple to yellow (Green et al. 1982). All the test extracts were treated with DPPH indicated their free radical scavenging potential. The standard ascorbic acid showed inhibition of 32% at 10 µg/100 µL with IC50 value 7.405 (µg/50 µL). The Bharmour, Kullu, Chamba, and Rampur showed the highest activity with IC50 values 25, 27, 28, and 33 (µg/50 µl), respectively, while Sundernagar, Palampur (HPK-4, HPKM-249, HPKM-317) showed the least activity (Fig. 6). The activity was found higher at high altitude in a dose-dependent manner. The activity might be due to the accumulation of primary and secondary metabolites under high altitudes environmental conditions. Similar findings were suggested by Kishore et al. (2010) in the buckwheat of different elevations. The results of the current study strongly support a hypothesis that relates the factors of altitudinal variation in the plant's secondary metabolism. This may be due to the low temperatures and long day lengths during the growth period of crops, which enhanced the biosynthesis rates of phenolics (Bilger et al. 2007).
Fig. 6.
Antioxidant activity of M. uniflorum samples
Amino acid screening using TLC
Amino acids play a significant role in human body metabolism, and pulses enriched in amino acids are essential for the progressive growth of an organism. TLC is the primary screening method for the presence of amino acids, while ninhydrin reagent was used as a detecting agent. TLC showed the presence of amino acid after derivatization with ninhydrin reagent as purple/violet color (Fig. 7).
Fig. 7.
TLC profile of amino acids
Amino acid profile
Seed samples from Rampur, Chamba, Bharmour and HPK-4 (Palampur) were found rich in eight amino acids (Serine, Glutamic acid, Proline, Threonine, Lysine, Tyrosine, Valine and nor valine), whereas, seed extract of Sundernagar contains 11 amino acids, with three of them are additional (Arginine, Aspargine, and Methionine). The arginine, asparagine, and methionine are observed in the detectable ratio. However, sulfur-containing amino acids remain a limiting factor in all seeds except seeds of the Sundernagar region (Methionine-0.103 µg/mg). Khader and Venkat Rao (1986) reported that methionine is the major limiting amino acid in horse gram while threonine and tryptophan are minor. Standard tablet of Cystone, which contains multiple ingredients, including crude extract of M. uniflorum. The tablet profile for amino acids showed the presence of 8 amino acids, out of which two glycine 0.282 µg/mg and alanine 0.410 µg/mg were present in significant quantifiable amount.
On the other hand, glutamic acid and valine were present in unquantifiable amount in Cystone therefore, it may be responsible for the high inhibition potential of seeds as compared to this herbal drug. Moreover, Sundernagar seeds were found rich in lysine (0.128 µg/mg) as compared with other samples, which makes seeds of this location as a better choice to a cereal-based diet instead of pigeon pea and chickpea (Venkatesha 1999; Prasad et al. 2010). The amino acid profile revealed that less explored and under-utilized horse gram seeds from Sundernagar can serve as a potential energy source, protein and food supplement for kidney stones, urinary tract problems, and livestock feed (Fig. 8; Table 1).
Fig. 8.
Chromatogram of standard amino acid mixture and M. uniflorum
Table 1.
Amino acid profiles of M. uniflorum samples and Cystone (Reference standard)
| Amino acid (µg/mg) | Cystone | HPK-4 | HPKM-249 | HPKM-317 | Rampur Local | Kullu Local | Chamba Local | Bharmour Local | S. Nagar Local |
|---|---|---|---|---|---|---|---|---|---|
| Histidine | – | – | – | – | – | – | – | – | – |
| Serine | 0.183 | 0.263 | 0.201 | 0.245 | 0.179 | 0.172 | 0.235 | 0.211 | 0.201 |
| Arginine | – | – | – | – | – | – | – | – | 0.116 |
| Glycine | 0.282 | – | – | – | – | – | – | – | – |
| Aspargine | – | – | – | – | – | – | – | – | 0.112 |
| Glutamic acid | – | 2.672 | – | – | 1.175 | 1.312 | 2.581 | 2.432 | 2.451 |
| Threonine | 0.338 | 0.249 | 0.235 | 0.224 | 0.226 | 0.254 | 0.272 | 0.245 | 0.290 |
| Alanine | 0.410 | – | – | – | – | 0.262 | – | – | 0.243 |
| Proline | 0.664 | 0.597 | 0.631 | 0.490 | 0.647 | 0.628 | 0.496 | 0.503 | 0.570 |
| Lysine | 0.100 | 0.071 | 0.077 | – | 0.087 | 0.075 | 0.085 | 0.069 | 0.128 |
| Tyrosine | 0.432 | 0.401 | 0.423 | 0.450 | 0.366 | 0.411 | 0.451 | 0.402 | 0.444 |
| Methionine | – | – | – | – | – | – | – | – | 0.103 |
| Valine | – | 0.633 | 0.918 | 0.599 | 0.522 | 0.573 | 0.640 | 0.713 | 0.983 |
| Nor-Valine | 1.264 | 0.635 | – | 0.552 | 0.529 | – | 0.635 | 0.624 | – |
| Isoleucine | – | – | – | – | – | – | – | – | – |
| Leucine | – | – | – | – | – | – | – | – | – |
| Phenyl alanine | – | – | – | – | – | – | – | – | – |
| Tryptophan | – | – | – | – | – | – | – | – | – |
Conclusion
In the current study, buffer and water extract of M. uniflorum seeds were found the most potential lead for the kidney stone degrading biocatalyst. The protein content was observed highest in the buffers and water extract with the different amino acid profiles and activity patterns. These alterations reflected the presence of different proteins and environmental factors. The activity might be due to the presence of polar compounds and proteins because ethanol and 50% ethanol do not show any significant activity. The results also actively support the higher accumulation of metabolites, antioxidants, and antilithiatic possibilities at higher altitudes, which directly and indirectly related to the secondary metabolism of plants. Screening of farmers' varieties for antilithiatic potential leads to provide the best varietal for further investigations. Hence, a detailed study is under progress for the isolation of inhibitory biocatalyst responsible for inhibition of CaOx crystal formation. The present findings will help in the development of more economical and reliable nutraceuticals.
Electronic supplementary material
Below is the link to the electronic supplementary material.
Acknowledgements
We are thankful DST-SERB (SERB/F/1597/2018-2019, dated 31 May, 2018), New Delhi for financial support and Department of Agricultural Biotechnology, CSK-HPKV, Palampur (H.P) for providing laboratory facilities. We are also thankful to Director, CSIR-IHBT and AnalytiCSIR-IHBT, Palampur (H.P) for the avail of instrumentation facility.
Abbreviations
- TLC
Thin layer chromatography
- UPLC
Ultra performance liquid chromatography
- DSHC
Di sodium hydrogen citrate
- DPPH
1,1-Diphenyl 2-picrylhyorazyl
- NR
Ninhydrin reagent
- CaOx
Calcium oxalate crystal
Compliance with ethical standards
Conflict of interest
Authors have no financial and commercial conflicts of interest and the study does not include experiments using animals and human’s nature.
Contributor Information
Manisha Gautam, Email: manisha.gautam21@gmail.com.
Rakesh Kumar Chahota, Email: rkchahota@yahoo.com.
References
- Abbagani S, Gundimeeda SD, Varre S, Ponnala D, Mundluru HP. Kidney stone disease: etiology and evaluation. Int J Appl Biol Pharm. 2010;1(1):175–182. [Google Scholar]
- Agrawal H, Joshi X, Gupta M. Purification, identification and characterization of two novel antioxidant peptides from finger millet (Eleusine coracana) protein hydrolysate. Food Res Int. 2019;120:697–707. doi: 10.1016/j.foodres.2018.11.028. [DOI] [PubMed] [Google Scholar]
- Ahmed S, Hasan MM, Mahmood ZA. Antiurolithiatic plants of family Fabaceae: a memoir of mechanism of action, therapeutic spectrum, formulations with doses. J Pharmacogn Phytochem. 2017;6(3):592–596. [Google Scholar]
- Anita SP, Hariprasad MP, Ankit SK, Surendra RM. A TLC-direct bioautography method for detection of antiurolithiatic metabolites. J Chromatogr Sci. 2017;55(5):571–577. doi: 10.1093/chromsci/bmx002. [DOI] [PubMed] [Google Scholar]
- Arulsekar S, Parfitt DE. Isozyme analysis procedures for stone fruits, almond, grape, walnut, pistachio and fig. HortScience. 1986;21:928–933. [Google Scholar]
- Bilger W, Rolland M, Nybakken L. UV screening in higher plants induced by low temperature in the absence of UV-B radiation. Photochem Photobiol Sci. 2007;6:190–195. doi: 10.1039/b609820g. [DOI] [PubMed] [Google Scholar]
- Binu TV, Vijayakumari B. Herbal plants as a remedy for urolithiasis: a review. Int J Pharm Sci Re s Develop. 2014;6(6):35–39. [Google Scholar]
- Bradford MM. A rapid and sensitive method for the quantitation of microgram quantities of protein utilizing the principle of protein-dye binding. Ann Biochem. 1976;72:248–254. doi: 10.1016/0003-2697(76)90527-3. [DOI] [PubMed] [Google Scholar]
- Doddola S, Pasuplati H, Konganti B, et al. Evaluation of Sesbaniagrandi flora for antiurolithiasic and antioxidant properties. J Nat Med. 2018;62:300–307. doi: 10.1007/s11418-008-0235-2. [DOI] [PubMed] [Google Scholar]
- Gautam M, Katoch S, Chahota RK. Comprehensive nutritional profiling and activity directed identification of lead antioxidant, antilithiatic agent from Macrotyloma uniflorum (Lam.) Verdc. Food Res Inter. 2020;109:600. doi: 10.1016/j.foodres.2020.109600. [DOI] [PubMed] [Google Scholar]
- Ghani A. Medicinal plants of Bangladesh: chemical constituents and uses. Dhaka: Asiatic Society of Bangladesh; 1998. p. 460p. [Google Scholar]
- Green LC, Wagner DA, Glogowski J, Skipper PL, Wishnok JS, Tannenbaum SR. Analysis of nitrate, nitrite and 15N in biological fluids. Anal Biochem. 1982;126:131–136. doi: 10.1016/0003-2697(82)90118-x. [DOI] [PubMed] [Google Scholar]
- Hadjzadeh MA, Khoei A, Hadjzadeh Z, Parizady M. Ethanolic extract of Nigella sativa L. seeds on ethylene glycol-induced kidney calculi in rats. Urol J. 2007;4(2):86–90. [PubMed] [Google Scholar]
- Halliwell B, Gutteridge JMC. Free radicals andtoxicology, free radicals in biology and medicine. Oxford: Claredon Press; 1997. pp. 1–27. [Google Scholar]
- Handa V, Kumar V, Panghal A, Suri S, Kaur J. Effect of soaking and germination on physicochemical and functional attributes of horsegram flour. J Food Sci Technol. 2017;54(13):4229–4239. doi: 10.1007/s13197-017-2892-1. [DOI] [PMC free article] [PubMed] [Google Scholar]
- Hennequin C, Lalanne V, Daudon M, Lacour B, Drueke T. A new approach to studying inhibitors of calcium oxalate crystal growth. Urol Res. 1993;21(2):101–108. doi: 10.1007/BF01788827. [DOI] [PubMed] [Google Scholar]
- Hostettmann K. Strategy for the biological and chemical evaluation of plant extracts. Pure Appl Chem. 1999;70(11):1–9. [Google Scholar]
- Kadam SS, Salunkhe DK, Maga JA. Nutritional composition, processing, and utilization of horsegram and moth bean. Crit Rev Food Sci. 1985;22:1–26. doi: 10.1080/10408398509527416. [DOI] [PubMed] [Google Scholar]
- Khader V, Venkat Rao S. Limiting amino acids in horsegram (Dolichos biflorus) Indian J Nutr Diet. 1986;23(6):158–164. [Google Scholar]
- Khan SR. Reactive oxygen species, inflammation and calcium oxalate nephrolithiasis. Transl Androl Urol. 2014;3(3):256–276. doi: 10.3978/j.issn.2223-4683.2014.06.04. [DOI] [PMC free article] [PubMed] [Google Scholar]
- Kishore K, Ranjan S, Pandey A, Gupta S. Influence of altitudinal variation on the antioxidant potential of tartar buckwheat of western Himalaya. Food Sci Biotechnol. 2010;19(5):1355–1363. [Google Scholar]
- Kumaran A, Karunakaran JR. In-vitro antioxidant activities of methanol extracts of five Phyllanthus species from India. J Food Sci Technol. 2005;40(2):344–352. [Google Scholar]
- Netrapal S, Satpal B, Sanjay G, Ajay K. Investigation the antilithiatic potential of horse gram (Macrotyloma uniflorum) seeds extracts on experimental kidney stones from high altitude of Uttarakhand (india) EJPMR. 2019;6:521–526. [Google Scholar]
- Pal RS, Bhartiya A, ArunKumar R, Kant L, Aditya JP, Bisht JK. Impact of dehulling and germination on nutrients, antinutrients, and antioxidant properties in horsegram. J Food Sci Technol. 2016;53(1):337–347. doi: 10.1007/s13197-015-2037-3. [DOI] [PMC free article] [PubMed] [Google Scholar]
- Patel VB, Acharya N. Anti-urolithiatic activities of macrotyloma uniflorum mediated through multiple pathway. IJPER. 2020;54(2):403–415. [Google Scholar]
- Pati CK, Bhattacharjee A. Seed potentiation of a horsegram cultivar by herbal manipulation. Int J Med Plants Res. 2013;2(1):152–155. [Google Scholar]
- Prasad RC, Upreti S, Thapa LB, Jirel PR, Mandal DN (2010) Food security and income generation of rural people through the cultivation of finger millet in Nepal. In: Mal B, Padulosi S and Bala Ravi S (Eds), Minor millets in South Asia. pp 107–146
- Prasad SK, Singh MK. Horse gram-an underutilized nutraceutical pulse crop: a review. J Food Sci Technol. 2015;52:2489–2499. doi: 10.1007/s13197-014-1312-z. [DOI] [PMC free article] [PubMed] [Google Scholar]
- Ranjan R, Matcha R, Madhuri B, Narendra Babu PVR. Comparative evaluation of protein extraction methods from few leguminous seeds. Int J Adv Biotechnol Res. 2012;3(2):558–563. [Google Scholar]
- Rupam V, Nazia D, Zia KH, Mular SM. Study on In vitro antiurolithiatic activity of Bryophyllum pinnatum and Ocimum gratissimum leaves. Biosci Discov. 2017;8(2):290–294. [Google Scholar]
- Santhoshi B, Chidrawar VR, Rao VU. A brief review on the potential medicinal plants and screening models of urolithiasis. Int J Appl Biol Pharm Technol. 2015;6(1):37–45. [Google Scholar]
- Senthil E. Evaluation of Dolichous bifiorus L. on high fructose diet induced alterations in albino rats. J Cell Tissue Res. 2009;9(1):1727–1730. [Google Scholar]
- Singh AK, Rehal J, Kaur A, Jyot G. Enhancement of attributes of cereals by germination and fermentation: a review. Crit Rev Food Sci and Nut. 2013;55:1575–1589. doi: 10.1080/10408398.2012.706661. [DOI] [PubMed] [Google Scholar]
- Singh J, Singh J, Kumar N, Jishtu V, Sharma S, Dhupper R. Ethno-medicinal plants used by indigenous people of Kanda Range, Chopal forest division, Himachal Pradesh. World J Pharm Pharm Sci. 2017;6(7):697–710. [Google Scholar]
- Srinivasa AKB, Kuruba L, Khan S, Gopi SS. Antiurolithiatic Activity of Gokhsuradi Churan, an Ayurvedic Formulation by In-Vitro Method. Adv Pharm Bull. 2013;3(2):477–479. doi: 10.5681/apb.2013.080. [DOI] [PMC free article] [PubMed] [Google Scholar]
- Stahl E. Thin Layer Chromatography (A Laboratory Handbook) New York: Springer; 1969. [Google Scholar]
- Venkatesha RT (1999) Studies on molecular aspects of seed storage proteins in horsegram (Dolichos bifίorus L.). Ph.D. thesis. Department of Food Microbiology Central, Food Technological Research Institute, Mysore, India
- Vidhya G, Sumithra G, Anandhan R, Anand G. Antiurolithiatic activity of Nardostachys jatamansi DC on modified lithogenic diet induced urolithiasis in rats. Int J Adv Pharm Res. 2013;2:52–63. [Google Scholar]
- Yadav RD, Alok S, Jain SK, Verma A, Mahor A, Bharti JP, et al. Herbal plants used in the treatment of urolithiasis: a review. Int J Pharm Res Technol. 2011;2(6):1412–1420. [Google Scholar]
- Yadava ND, Vyas NL. Arid legumes. India: Agro Botanical Publishers; 1994. Horsegram; pp. 64–75. [Google Scholar]
- Ying Z, Han X, Li J. Ultrasound-assisted extraction of polysaccharides from mulberry leaves. Food Chem. 2011;127:1273–1279. doi: 10.1016/j.foodchem.2011.01.083. [DOI] [PubMed] [Google Scholar]
Associated Data
This section collects any data citations, data availability statements, or supplementary materials included in this article.